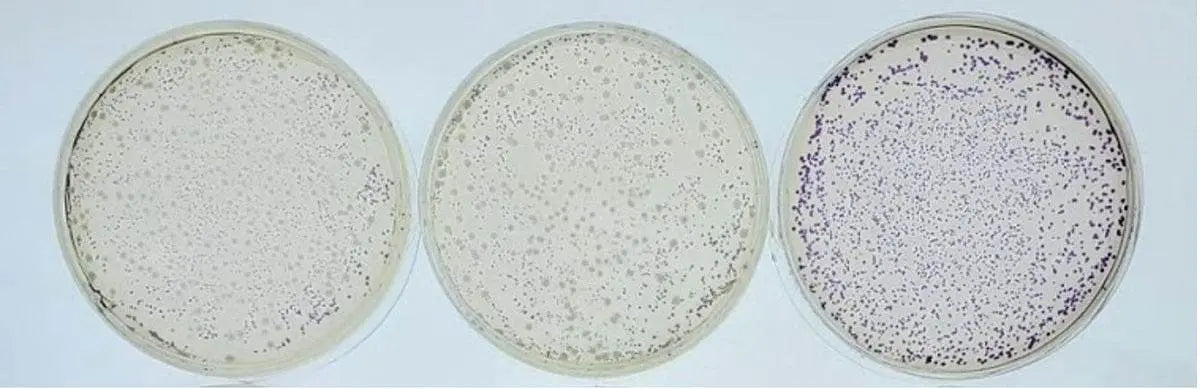
Battling Bacteria - Kormay Biomedicals store

Biotechnology Education
Showing 37 - 72 of 284 products
Display
View

EDVOTEK
MyLab™ Custom Kit for Distance Learning - Simulation of COVID-19 Antibody Test
Sale price$76.00 CAD
Filters (0)